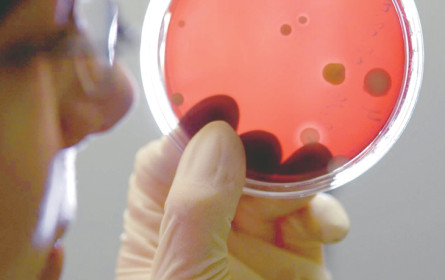
EU-Plattform gegen Antibiotikaresistenzen

Wien. Die Antibiotikaresistenz ist ein wichtiges globales Problem, das in der EU und den USA allein mindestens 50.000 Menschenleben pro Jahr fordert. Im Jahr 2050 wird die Antibiotikaresistenz potenziell zu einer globalen wirtschaftlichen Belastung von bis zu 100 Billionen US-Doller führen, schätzt die WHO.
Die Gründungsmitglieder der BEAM Alliance (Biotechs from Europe innovating in Anti-Microbial resistance) haben nun den Start einer europaweiten Initiative bekannt gegeben, die durch übergreifende antimikrobielle Forschungs- und Entwicklungsstrategien darauf zielt, multiresistente Bakterien zu bekämpfen.
Deren Entwicklung führt zu einer weltweiten Krise der öffentlichen Gesundheitsversorgung. Biotechnologie-Unternehmen sind die treibende Kraft bei der Bekämpfung, sei es durch das Design und die Entwicklung von neuen Antibiotika, durch die Identifizierung und Umsetzung von Präventionsstrategien gegen die Resistenzbildung oder durch die Entwicklung verbesserter diagnostischer Technologien, die eine zielgerichtete und angemessene antibiotische Behandlung erleichtern können.
In der BEAM Alliance sind 37 auf Antibiotika-Forschung und Entwicklung fokussierte Biotech-Unternehmen aus zehn europäischen Ländern zusammengeschlossen – darunter die Wiener Arsanis Biosciences GmbH. Sie eint die Vision, Fortschritte bei der Bekämpfung der Antibiotika-Resistenz zu beschleunigen und die zukünftige Entwicklung erworbener Resis-tenzen in Krankheitserregern zu minimieren.
Gesamtziel von BEAM ist es, das europäische Umfeld für die Forschung, Entwicklung und Vermarktung neuer Produkte zur Überwindung der Antibiotika-Resistenz im regulatorischen, Investitions- und Marktbereich zu verbessern. Florence Séjourné vom französischen Biotech-Unternehmen Da Volterra erläuterte, dass „Investitionen in Forschung und Entwicklung von Antibiotikatherapien, neuartigen Ansätzen und Diagnostik unverkennbar von kleineren, innovativen Biotech-Unternehmen kommen”.(iks)